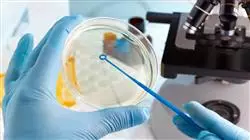
##IMAGE##

Universitäre Qualifikation
Die größte Fakultät für Medizin der Welt"
Präsentation
Mit diesem Abschluss erweitern Sie Ihre Fähigkeiten in der Anwendung von Methoden wie High-Throughput oder Real-Time PCR für genetische Studien"
Die genomische Ernährung hat sich in der Medizin zunehmend als wirksame Methode zur Vorbeugung oder Behandlung verschiedener Krankheiten etabliert. Infolgedessen haben sich die Techniken zur Durchführung genetischer Studien im Labor erheblich weiterentwickelt, um sie in kurzer Zeit und mit höchster Genauigkeit durchführen zu können. Da nicht nur der Erfolg der Analyse, sondern auch die Optimierung der anschließenden Therapie mit dem Patienten von dieser Arbeit abhängt, müssen sich die Ärzte dieser Fortschritte bewusst sein und sie in ihrer täglichen Arbeit richtig anwenden, um ihre berufliche Entwicklung in der Welt der genomischen Ernährung zu vervollkommnen.
Angesichts dieser Situation hat TECH beschlossen, dieses Programm einzurichten, mit dem die Studenten sich innovative Labortechniken aneignen können, die es ermöglichen, DNA-Studien schnell, einfach und mit hervorragenden Ergebnissen durchzuführen, um anschließend die Ernährung erfolgreich an die genetischen Merkmale jeder Person anzupassen. In einem 6-wöchigen Intensivkurs erlernen sie die neuesten Protokolle für die DNA-Sequenzierung oder erfahren mehr über die Biomarker von Metabolomik oder Metagenomik. Außerdem werden modernste Bioinformatiksoftware und -werkzeuge für den Abruf und die Speicherung der gewonnenen genetischen Daten eingesetzt.
Dank der 100%igen Online-Methode, die für diesen universitätskurs charakteristisch ist, können die Teilnehmer ihre Zeit selbst einteilen und in ihrem eigenen Tempo arbeiten, um ein effizientes Lernen zu ermöglichen. Darüber hinaus haben sie Zugang zu Lehrinhalten, die auf Medien wie ergänzende Lektüre oder Erklärvideos verfügbar sind, so dass sie ihren Lernprozess an die jeweiligen Studienanforderungen anpassen können.
Der universitätskurs in Labortechniken für Genomische Ernährung wird Sie in die Lage versetzen, die Biomarker von Metabolomik oder Metagenomik genau zu handhaben"
Dieser universitätskurs in Labortechniken für Genomische Ernährung enthält das vollständigste und aktuellste wissenschaftliche Programm auf dem Markt. Die wichtigsten Merkmale sind:
- Die Entwicklung von Fallstudien, die von Experten für Genom- und Präzisionsernährung vorgestellt werden
- Der anschauliche, schematische und äußerst praxisnahe Inhalt vermittelt alle für die berufliche Praxis unverzichtbaren wissenschaftlichen und praktischen Informationen
- Praktische Übungen, bei denen der Selbstbewertungsprozess zur Verbesserung des Lernens genutzt werden kann
- Sein besonderer Schwerpunkt liegt auf innovativen Methoden
- Theoretische Vorträge, Fragen an den Experten, Diskussionsforen zu kontroversen Themen und individuelle Reflexionsarbeit
- Die Verfügbarkeit des Zugriffs auf die Inhalte von jedem festen oder tragbaren Gerät mit Internetanschluss
Kombinieren Sie Ihr Lernen mit Ihren beruflichen Pflichten dank des vollständig online durchgeführten Studiums"
Das Dozententeam des Programms besteht aus Fachleuten aus der Branche, die ihre Erfahrungen aus ihrer Arbeit in diese Fortbildung einbringen, sowie aus anerkannten Spezialisten von führenden Gesellschaften und renommierten Universitäten.
Die multimedialen Inhalte, die mit der neuesten Bildungstechnologie entwickelt wurden, werden der Fachkraft ein situiertes und kontextbezogenes Lernen ermöglichen, d. h. eine simulierte Umgebung, die eine immersive Fortbildung bietet, die auf die Ausführung von realen Situationen ausgerichtet ist.
Das Konzept dieses Programms konzentriert sich auf problemorientiertes Lernen, bei dem die Fachkraft versuchen muss, die verschiedenen Situationen aus der beruflichen Praxis zu lösen, die während des gesamten Studiengangs gestellt werden. Zu diesem Zweck wird sie von einem innovativen interaktiven Videosystem unterstützt, das von renommierten Experten entwickelt wurde.
Eignen Sie sich dank dieses Universitätskurses, den TECH Ihnen anbietet, die neuesten DNA-Sequenzierungsprotokolle an"
Mit einem einfachen Smartphone mit Internetanschluss können Sie dieses Programm von überall aus nutzen"
Ziele und Kompetenzen
Dieser universitätskurs wurde mit der Absicht entwickelt, dem Arzt die neuesten und effizientesten Labortechniken zur Durchführung verschiedener Studien im Bereich der genomischen Ernährung zu vermitteln. Auf diese Weise wird er sich mit den ausgefeilten Methoden der DNA-Extraktion oder dem Einsatz modernster Bioinformatik-Tools befassen und somit eine ausgezeichnete Lernerfahrung dank der folgenden allgemeinen und spezifischen Ziele von TECH erzielen.
Integrieren Sie die neuesten Fortschritte in Bezug auf Labortechniken für Genomische Ernährung in Ihre Arbeitsmethodik"
Allgemeine Ziele
- Erwerben von theoretischem Wissen über die menschliche Populationsgenetik
- Erwerben von Kenntnissen über genomische und Präzisionsernährung, um diese in der klinischen Praxis anwenden zu können
- Lernen der Entwicklung dieses innovativen Bereichs und der wichtigsten Studien, die zu seiner Entstehung beigetragen haben
- Wissen, bei welchen Krankheiten und Lebensumständen die Genom- und Präzisionsernährung eingesetzt werden können
- In der Lage sein, die individuelle Reaktion auf Ernährung und Ernährungsmuster zu beurteilen, um die Gesundheit zu fördern und Krankheiten vorzubeugen
- Verstehen, wie die Ernährung die Genexpression beim Menschen beeinflusst
- Lernen der neuen Konzepte und zukünftigen Trends auf dem Gebiet der Genom- und Präzisionsernährung
- In der Lage sein, personalisierte Ernährungs- und Lebensstilgewohnheiten je nach genetischen Polymorphismen anzupassen
- Bereitstellen von aktuellem Wissen auf dem Gebiet der Genom- und Präzisionsernährung für Angehörige der Gesundheitsberufe, damit diese wissen, wie sie es in ihrer beruflichen Tätigkeit anwenden können
- Alle aktuellen Erkenntnisse in die richtige Perspektive rücken, um zu wissen, wo man heute steht und wohin man sich bewegt, damit der Student die ethischen, wirtschaftlichen und wissenschaftlichen Implikationen auf diesem Gebiet abschätzen kann
Spezifische Ziele
- Verstehen der Techniken, die in Studien zur Ernährungsgenomik verwendet werden
- Beherrschen modernster DNA-Extraktionstechniken
- Erlernen der neuesten Fortschritte, die in den Bereichen omics-Techniken und Bioinformatik erforderlich sind
- Verwenden der modernsten Bioinformatiksoftware sowie -werkzeuge
Gemäß den allgemeinen und spezifischen Zielen, die TECH für diesen Abschluss festgelegt hat, werden Sie sich eine Reihe von Fähigkeiten aneignen, die Ihnen helfen werden, Ihre Leistungen im Labor zu perfektionieren"
Universitätskurs in Labortechniken für Genomische Ernährung
Entdecken Sie das faszinierende Gebiet der genomischen Ernährung und erwerben Sie die notwendigen technischen Fähigkeiten mit dem Universitätskurs in Labortechniken für Genomische Ernährung der TECH Technologischen Universität. Dieses auf die berufliche Weiterbildung ausgerichtete Programm bietet Ihnen die Möglichkeit, Ihr Wissen im Online-Modus zu erweitern und dabei alle Vorteile zu nutzen, die diese Modalität zu bieten hat. Der Universitätskurs in Labortechniken für Genomische Ernährung bietet Ihnen eine spezialisierte Weiterbildung in den gebräuchlichsten Labortechniken und Werkzeugen im Bereich der Genomischen Ernährung. Sie werden lernen, modernste Geräte und Software zu benutzen, biologische Proben zu analysieren und die erhaltenen Ergebnisse zu interpretieren. Sie erwerben praktische und theoretische Fähigkeiten, die Sie in die Lage versetzen, zum Fortschritt der Forschung auf diesem hochmodernen Gebiet beizutragen. Unser Programm verfügt über ein Team von Dozenten, die Experten auf dem Gebiet der genomischen Ernährung sind und über Erfahrung in Forschungslabors verfügen. Darüber hinaus haben Sie Zugang zu modernsten technologischen Ressourcen wie virtuellen Labors und spezialisierten Datenbanken, die Ihnen eine bereichernde und aktuelle Lernerfahrung bieten werden. Nach Abschluss des Universitätskurses in Labortechniken für Genomische Ernährung sind Sie in der Lage, Ihr Wissen in Forschungslabors, Ernährungskliniken, Biotechnologieunternehmen und anderen verwandten Berufsfeldern anzuwenden. Sie werden in der Lage sein, genetische und molekulare Analysen durchzuführen, die erhaltenen Ergebnisse zu interpretieren und zur Entwicklung von personalisierten Ernährungsstrategien auf der Grundlage der Genomik beizutragen.
Schreiben Sie sich jetzt ein und beginnen Sie, Ihre berufliche Karriere voranzutreiben
Die TECH Technologische Universität weiß, wie wichtig Flexibilität und Zugänglichkeit in der Weiterbildung sind. Unser Online-Programm ermöglicht es Ihnen, von überall und zu jeder Zeit zu studieren, die in Ihren Zeitplan passt. Sie müssen sich keine Gedanken mehr über das Pendeln, starre Zeitpläne oder geografische Barrieren machen. Sie können in Ihrem eigenen Tempo studieren, das Beste aus Ihrer Zeit machen und Ihr Studium an Ihre persönlichen und beruflichen Verpflichtungen anpassen.